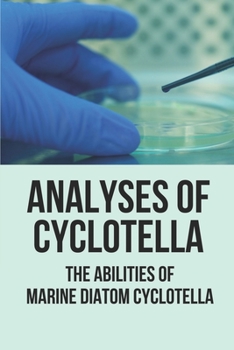
Paperback Analyses Of Cyclotella: The Abilities Of Marine Diatom Cyclotella: Study Microalgae Book

Analyses Of Cyclotella: The Abilities Of Marine Diatom Cyclotella: Study Microalgae
No Synopsis Available.
Format:Paperback
Language:English
ISBN:B0989TW9SP
ISBN13:9798528666631
Release Date:June 2021
Publisher:Independently Published
Length:48 Pages
Weight:0.18 lbs.
Dimensions:0.1" x 6.0" x 9.0"
Customer Reviews
0 rating